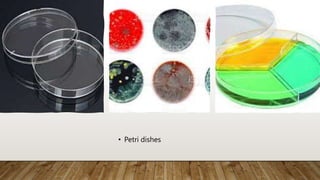
• Petri dishes

The document outlines the necessary requirements and equipment for water quality laboratories, emphasizing the importance of proper signage, equipment calibration, and in-house expertise for accreditation. It includes a detailed inventory of lab instruments, chemical handling safety measures, and layout considerations for effective laboratory management. Additionally, it presents recommendations for waste segregation, maintenance of equipment, and the establishment of a lab inventory system.